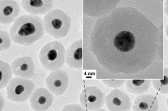
정보저장능력 뛰어난 유기 메모리 소자 개발

산업일보 "이강은"에 대한 검색결과입니다.
뉴스

천연가스 직접 연료 사용 연료극 소재 개발
이강은 기자 2014.12.25수소와 공기만으로 전기를 발생시키는 고체 산화물 연료전지의 새로운 전극소재가 개발됐다. 천연가스, LPG 등 기존 탄화수소 계열 연료를 직접 사용할 수 있고 성능과 안정성도 뛰어난 소재로 탄화수소 사용시 나타날 수 있는..

2016년까지 25개 노후 산단 리모델링 단지 지정
이강은 기자 2014.12.24정부가 내년 11개 리모델링 산단 선정을 당초보다 1년 앞당겨 시행키로 했다. 국토교통부(장관 서승환)와 산업통상자원부(장관 윤상직)는 전국 노후 산업 단지를 대상으로 기반시설 노후도, 혁신역량 등을 진단하고 산단 특성에..
조달청,'신화랑 풍류체험 벨트 조성 등 총 82건, 2,509억 원 상당 입찰 예정
이강은 기자 2014.12.23조달청(청장 김상규)은 이번 주(22일부터 26일까지)에 ’신화랑풍류체험벨트조성사업(건축·조경공사)‘ 등 82건 약 2,509억 원 상당의 공사입찰을 집행할 예정이다. 입찰은 ‘부산지방법원 서부지원청사 신축 건축공사 ‘ 등..
정보저장능력 뛰어난 유기 메모리 소자 개발
이강은 기자 2014.12.23국내 연구진이 유기메모리소자의 가장 큰 단점인 정보저장능력을 크게 향상시킬 수 있는 기술을 개발했다. 또한 제작공정도 단순화 시킬 수 있어 향후 값싸고, 휘거나 접을 수 있는 장점을 지닌 유기메모리 소자의 상용화에 크게 ..

화학사고에서 산업재해까지…사고 예방법 기업에서 듣는다
이강은 기자 2014.12.21환경부(장관 윤성규)·산업통상자원부(장관 윤상직)·고용노동부(장관 이기권)가 합동으로 주최한 ‘아차사고 사례 공모전’ 시상식이 17일 중소기업중앙회에서 열렸다. 아차사고란 작업자의 부주의나 현장 설비 결함 등으로 사..

화학사고 예방, CEO 의지가 중요
이강은 기자 2014.12.20경기도는 18일 수원 라마다호텔에서 도내 유해화학물질 취급사업장 최고경영자(CEO) 130여 명을 대상으로 ‘유해화학물질 맞춤형 안전교육’을 실시했다. 이번 교육은 경기도가 직무와 직책에 적합한 실용교육과 관리자 의식전환의 ..
3D프린터, 레이저커터 등 장비 무료 지원하는 ‘디지털 공방’
이강은 기자 2014.12.19창의적인 아이디어와 개발능력을 보유한 개인에게 스마트 디바이스를 직접 만들어 볼 수 있도록 모든 것을 지원하는 ‘창의 디바이스랩’이 17일 개소식과 함께 판교테크노밸리 공공지원센터에서 문을 연다. 창의 디바이스랩은 ..

Seco, Jabro® 제품군에 황삭 및 소직경 4 플루트 엔드밀 추가
이강은 기자 2014.12.19Seco는 최근 직경 16mm 및 20mm의 Jabro-HPM JHP951 황삭 엔드밀과 Jabro-Mini JM905 및 JM920 소직경 엔드밀에 4 플루트 디자인을 추가했다. 이번 추가로 Seco의 프리미엄 솔리드 초경 제품군의 기능이 더욱 확장될 전망이다. 기존..

한국기계연구원, 따뜻한 마음 담은 ‘사랑의 연탄배달’
이강은 기자 2014.12.18미래창조과학부 산하 한국기계연구원(원장 임용택)은 17일 오후, 유성구 관내 저소득가정을 위한 ‘사랑의 연탄배달’ 시간을 가졌다. 한국기계연구원 임용택 원장을 비롯한 직원들이 5개 가정에 가구당 500장씩의 연탄을 배..

국가경쟁력 향상 신기술 22개 인증
이강은 기자 2014.12.18산업통상자원부 국가기술표준원은 경제적 파급효과가 크고 국가 경쟁력 향상에 이바지할 22개의 새로운 기술을 선정하고, 2014년도 제3회 신기술(NET : New Excellent Technology) 신기술인증서를 수여했다. 신기술(NET) 인증은..





![[카드뉴스] 전북, 방산 산업의 핵심 ‘탄소복합소재’ 중심지로 썸네일 이미지](http://pimg3.daara.co.kr/kidd/photo/2026/04/16/thumbs/thumb_168126_1776322224_16.jpg)























![[SIMTOS 2026] 한국지멘스, AI·디지털 트윈 기반 ‘소프트웨어 정의 제조’ 전략 제시](http://pimg3.daara.co.kr/kidd/photo/2026/04/22/thumbs/thumb_520390_1776822418_73.jpg)




